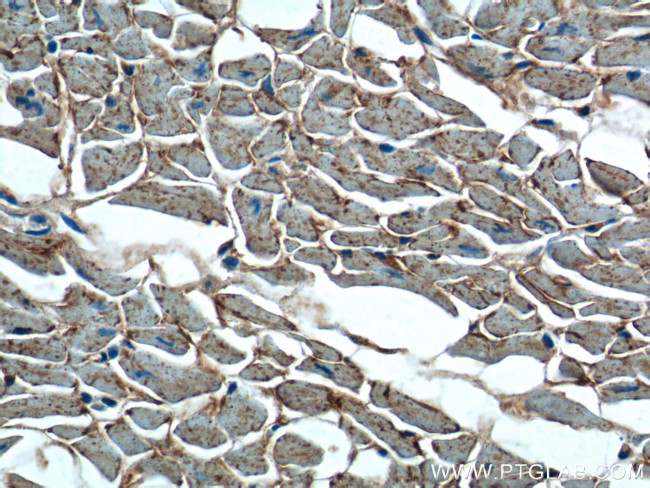
OLR1 Antibody in Immunohistochemistry (Paraffin) (IHC (P))

Search
Proteintech
OLR1 Polyclonal Antibody
{{$productOrderCtrl.translations['antibody.pdp.commerceCard.promotion.promotions']}}
{{$productOrderCtrl.translations['antibody.pdp.commerceCard.promotion.viewpromo']}}
{{$productOrderCtrl.translations['antibody.pdp.commerceCard.promotion.promocode']}}: {{promo.promoCode}} {{promo.promoTitle}} {{promo.promoDescription}}. {{$productOrderCtrl.translations['antibody.pdp.commerceCard.promotion.learnmore']}}
产品信息
11837-1-AP
种属反应
已发表种属
宿主/亚型
分类
类型
抗原
偶联物
形式
浓度
规格
纯化类型
保存液
内含物
保存条件
运输条件
产品详细信息
Immunogen sequence: MTFDDLKIQ TVKDQPDEKS NGKKAKGLQF LYSPWWCLAA ATLGVLCLGL VVTIMVLGMQ LSQVSDLLTQ EQANLTHQKK KLEGQISARQ QAEEASQESE NELKEMIETL ARKLNEKSKE QMELHHQNLN LQETLKRVAN CSAPCPQDWI WHGENCYLFS SGSFNWEKSQ EKCLSLDAKL LKINSTADLD FIQQAISYSS FPFWMGLSRR NPSYPWLWED GSPLMPHLFR VRGAVSQTYP SGTCAYIQRG AVYAENCILA AFSICQKKAN LRAQ (1-273 aa encoded by BC022295)
靶标信息
LOX-1 (lectin-like oxidized LDL receptor -1) is a 40-50 kDa type II membrane glycoprotein class E scavenger receptor expressed by endothelial cells, macrophages, activated platelets and smooth muscle cells. LOX-1 binds to a wide range of ligands, including oxidized low-density lipoprotein (oxLDL), hypochlorite modified high-density lipoprotein (HDL), aged /apoptotic cells, activated platelets and bacteria, reflecting its versatile physiological functions.
仅用于科研。不用于诊断过程。未经明确授权不得转售。
生物信息学
蛋白别名: C-type lectin domain family 8 member A; hLOX 1; hLOX-1; hLOX1; Lectin-like oxidized LDL receptor 1; Lectin-type oxidized LDL receptor 1; LOX 1; LOX-1; ox LDL receptor 1; Ox-LDL receptor 1; oxidized low density lipoprotein (lectin-like) receptor 1; Oxidized low-density lipoprotein receptor 1; oxidized low-density lipoprotein receptor 1, soluble form; scavenger receptor class E, member 1; sLOX 1; soluble LOX 1; unnamed protein product
基因别名: CLEC8A; LOX1; LOXIN; OLR1; SCARE1; SLOX1
UniProt ID: (Human) P78380
Entrez Gene ID: (Human) 4973